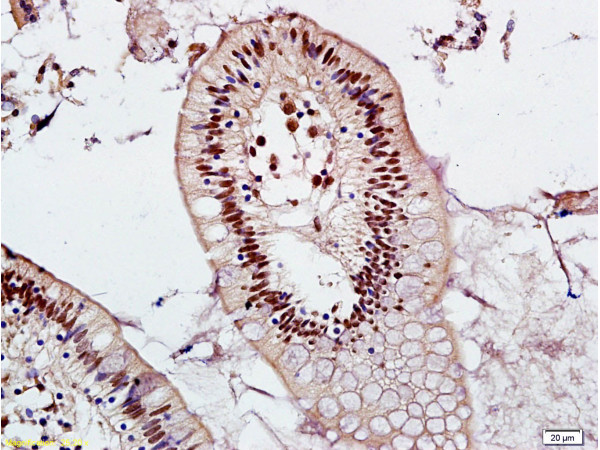
Formalin-fixed and adjacent noncancerous of human colon tissue labeled with Anti-Mel18/ZNF144 Polyclonal Antibody, Unconjugated (bs-9673R) at 1:200 followed by conjugation to the secondary antibody and DAB staining

Western blot analysis in A549 cell line lysates (35ug/lane) using RNF110 / PCGF2 antibody. This demonstrates the PCGF2 antibody detected the PCGF2 protein (arrow).
Mel18 (PCGF2) (Center) Rabbit Polyclonal Antibody
AP53218PU-N
ApplicationsWestern Blot
Product group Antibodies
TargetPCGF2
Overview
- SupplierOriGene
- Product NameMel18 (PCGF2) (Center) Rabbit Polyclonal Antibody
- Delivery Days Customer14
- ApplicationsWestern Blot
- CertificationResearch Use Only
- ClonalityPolyclonal
- Gene ID7703
- Target namePCGF2
- Target descriptionpolycomb group ring finger 2
- Target synonymsMEL-18, RNF110, TPFS, ZNF144, polycomb group RING finger protein 2, DNA-binding protein Mel-18, ring finger protein 110, zinc finger protein 144
- HostRabbit
- Protein IDP35227
- Protein NamePolycomb group RING finger protein 2
- Scientific DescriptionMel18 (PCGF2) (Center) rabbit polyclonal antibody, Aff - Purified
- Storage Instruction-20°C,2°C to 8°C
- UNSPSC12352203